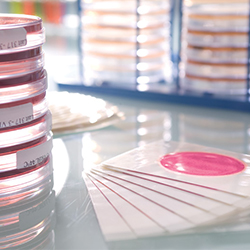
April Star Buy - 3M Petrifilm Aerobic Count Plates Image

10 December 2018ARCHIVED
Christmas Opening Hours
Please see below for our opening times over the Christmas period:
| Date | Opening Times |
| Monday, Chistmas Eve | Normal opening hours |
| Tuesday, Christmas Day | Closed |
| Wednesday, 26th December | Closed |
| Thursday, 27th December | 10am - 3pm |
| Friday, 28th December | 10am - 3pm |
| Monday, New Years Eve | 10am - 3pm |
| Tuesday, New Years Day | Closed |
| Wednesday, 2nd January 2019 | Normal opening hours |
Last shipment/despatch prior to the Christmas break is Tuesday 18th December 2018.
No shipments will be made between 19th – 26th December 2018. During this time a full physical stock count will take place.
Limited shipments will resume on 27th, 28th and 31st December 2018.
Business reopens on Wednesday 2nd January 2019.
If you have any questions about this, please contact us.
Merry Christmas and Happy New Year from all at SLS Select Education!
READ MORE

07 December 2018ARCHIVED
December Star Buy - 1L Compact Stirrer
The last Star Buy of 2018 is this 1L Compact Stirrer, suggested by SLS Select Education rep Lynn.
Lynn recommends this product because it's a very compact and robust magnetic stirrer, ideal for Prep Room use. This product is supplied with 2 stirrer bars and a 3 year warranty.
Want to know more? Visit the link below!
Visit web link »

03 December 2018ARCHIVED
5 Days of Christmas Competition Terms and Conditions
We're running a Christmas competition where you can be in with a chance of winning one of five fantastic prizes, including: a £5 Starbucks gift card, a bottle of prosecco, a pair of science socks, a £25 Showcase voucher and a Christmas hamper!
Simply enter the quiz question on the page below and submit the form to enter. Then keep an eye on our Twitter feed next week where one winner will be announced each day.
Full Terms & Conditions below.
Visit web link »
READ MORE

22 November 2018ARCHIVED
A Day in the Life of a Science Technician
Our team of sales representatives at SLS Select Education are all former Science Technicians, and our customer base mainly consists of technicians working in school science departments.
But what does an average day look like for our customers, if there is such a thing? We interviewed Chris Pambou, Chief Science Technician at City and Islington Sixth Form College and developer of the Labexpert UK Chemical & Equipment Stock Control Database Software, to find out.
READ MORE

15 November 2018ARCHIVED
November Star Buy - MKL Electronic Balance
Our Star Buy for this month was nominated by Select Education rep for Northern Ireland, Rodney, and is this MKL Electronic Balance!
This product features two decimal place readability, a mains power adapter and optional AA batteries. It can be stacked for storage and transportation and has overload protection. This Balance is a very economical solution in the classroom where two decimal place accuracy is required.
Find out more and order yours below.
Visit web link »

06 November 2018ARCHIVED
Request a Rep Competition Terms and Conditions
Request a visit from your local SLS Select Education rep in November and be in with a chance of winning a £50 Amazon voucher!
Simply email [email protected] with your school name and address to enter.
Full Terms & Conditions of the competition can be found below.
READ MORE

05 November 2018ARCHIVED
Savings on Rasotherm!
Introducing RASOTHERM® laboratory glassware!
RASOTHERM® represents a selected range of high quality laboratory glass products. This new range of borosilicate glass 3.3 products conforms to all relevant international ISO standards for Laboratory ware.
RASOTHERM® glassware is a ‘mid-range’ brand designed specifically for use in school laboratories providing users with a perfect combination of quality and price. RASOTHERM® is a brand of DWK Life Sciences.
Get 10% off the range as an introductory offer, view the full brochure below.
READ MORE

22 October 2018ARCHIVED
How to Become a School Science Technician
Our team of sales representatives at SLS Select Education are all former Science Technicians, and our customer base mainly consists of technicians working in school science departments.
But for anybody thinking of a career in school science, what does the job of a School Science Technician entail? And how do you get started?
READ MORE

15 October 2018ARCHIVED
October Star Buy - Vibration Generator
Our Star Buy for this month was nominated by Select Education rep for Northern Ireland, Rodney, and is this Vibration Generator!
We can hear sound but we can’t see it. A vibration generator allows pupils to easily visualise sound waves. Pupils can see the various effects made by different frequencies. The Vibration Generator also gives mechanical oscillations when fed by signals from a Signal Generator.
Find out more about this excellent product and related accessories, and order yours, below!
Visit web link »

08 October 2018ARCHIVED
Sign Up To Our Mailing List For a Chance To Win A Kern Balance
Throughout October, new subscribers to our mailing list will be entered into a prize draw to win a Kern Precision Balance worth over £130!
Simply sign up to our email marketing list here by the end of the month to enter.
See full Terms & Conditions below.
READ MORE

27 September 2018ARCHIVED
SYC - Secure your Chemicals
We are often asked questions by our customers on how schools should secure chemicals.
This SYC guide has been written by the Home Office in collaboration with the Health and Safety Executive (HSE), CLEAPSS and SSERC and aims to improve the security of hazardous chemicals that are used in secondary and tertiary education.
Download your copy below!
READ MORE

20 September 2018ARCHIVED
September Star Buy - Lascells Loudspeaker Kit
This month's Star Buy was nominated by SE rep Allison - it's the Lascells Loudspeaker Kit.
Students can use this kit to construct a simple loudspeaker from scratch, giving them practical experience of sound and electromagnetism. Ideal for STEM clubs, feeder days or open nights!
This kit provides all you need to construct 10 loudspeakers.
Find out more about this fantastic product and order yours below!
Visit web link »

19 September 2018ARCHIVED
Your Chosen Supplier For Pyrex, Quickfit, Azlon and MBL
We are delighted to announce that we have been chosen as a preferred school supplier of Scilabware products. This includes all Pyrex® and Quickfit® glassware, Azlon® plasticware and MBL® volumetrics. Scilabware apparatus has an unrivalled reputation for quality, safety and performance and we are proud that we have been chosen to represent them as a preferred distributor.
Read more here.
“This will allow SLS Select Education to work closely with both the Education market on our brands, provide more detailed information on the products, CPD information, workshops and support for the science technicians.” – Marc Hurn, Director, Scilabware
Read the full letter from Scilabware below.
10% off on selected Pyrex lines in our Economy vs. Premium promotion!
READ MORE

10 September 2018ARCHIVED
Back to School Promotions Out Now - 10% Off Everything!
Our new Back to School promotional brochure is out now! Including a selection of fantastic products, with economy and premium options available. Everything in the brochure is 10% off!
Find out more about these excellent offers below. Browse the e-catalogue online, or download a PDF.
Visit web link »

05 September 2018ARCHIVED
Our Gauze Products Are Certified Safe
Following the recent press release issued by CLEAPSS and HSE involving the supply of ceramic gauze containing asbestos into schools, we have tested all related products through UKAS accredited laboratories and can confirm they have been approved as safe to use and asbestos-free.
The relevant certificates are available to view or download on the product pages of our website for reference:
https://www.science2education.co.uk/product/GAU1004#tab-4
https://www.science2education.co.uk/product/GAU1006#tab-4
We will also be extending the asbestos testing to other products to ensure our customers have full confidence in the quality of products we supply.
For more information, please feel free to contact our customer service team.

10 August 2018ARCHIVED
August Star Buy - Hand-Held Refractometer
This month's Star Buy product has been been suggested by Gary D'Cruz, our Technical Sales Manager for the South of England. It's this Hand-Held Refractometer, which is available from SLS Select Education for £95.92 each!
Gary had this to say about this product:
"Nice piece of kit when teaching health which measures the sugar content of different liquids. It is mainly used for
quick measurements in the medical and veterinary market. A selection of refractometers are available to measure the sugar content
in different percentage ranges."
Find out more, see the full range and order yours below!
Visit web link »

06 August 2018ARCHIVED
Advice on the Safe Storage and Disposal of Chemicals
During the quieter summer period, we often receive calls from schools asking for advice on how to safely store and dispose of the chemicals we supply.
Attached is the official government guidelines on this which our customers may find useful. For further information or advice, please feel free to contact us.
READ MORE

23 July 2018ARCHIVED
Physics Equipment From Inspire - Introductory Pricing Until April 2019
Inspire is a brand new range of apparatus designed by Physics teachers specifically to meet the requirements of the latest Physics curriculum. Inspire includes a suite of innovative Bluetooth timing devices, a range of robust power supplies, cost effective meters and other equipment.
Take a look at the range below and our fantastic introductory pricing, available until 30th April 2019.
Visit web link »

18 July 2018ARCHIVED
July Star Buy - Lascells Simple Timer!
This month's Star Buy product has been nominated by our Technical Sales Manager for the South of England, Gary D'Cruz.
It's the Lascells Simple Timer. The Simple Timer is an easy to use, standalone kit to measure time, speed, velocity or acceleration between light gates. Gary particularly likes this product, as it's a good alternative option for customers that do not have (or do not enjoy!) data
logging.
Features include a clear, 4 digit LED display; three sockets provide START and STOP inputs, making triggering very simple and reliable; 3.5mm sockets to allow Lascells timer light gates to be connected; it is supplied with a mains plug-top adaptor and full instructions.
Order yours below or contact us for more information.
Visit web link »

20 June 2018ARCHIVED
We're Sponsoring a Labexpert Training Workshop on 11th July in London
We're proud to be sponsoring a Labexpert Training Workshop on Wednesday 11th July at the City and Islington Sixth Form College in London.
The course is ideal for staff using the Labexpert UK Chemical and Equipment Stock Control Software or for those who would like to learn more about stock control systems. The programme will focus on chemical storage which will include factors affecting the storage of chemicals, the law, location and type of stores and chemical storage groups including GHS/CLP. This will be a hands-on training session on how best to use the Labexpert UK Chemical & Equipment Stock Control Software. Also including the use of barcode scanners and label printers.
Cost: £70 (includes lunch and refreshments) plus a 10% Discount Voucher from Labexpert, a £10 voucher for SLS Select Education and a good bag!
TO BOOK A PLACE PLEASE EMAIL [email protected].
READ MORE

13 June 2018ARCHIVED
June Star Buy - Lascells Cloud Chamber!
This month's Star Buy has been nominated by SLS Select Education Technical Support Officer Sharon, it's the Lascells Cloud Chamber!
Here's what Sharon has to say about this excellent product:
"Radiation is a subject whereby it is difficult to see good visual results. This Cloud Chamber makes the invisible
visible! With this product there is no need for dry ice and with the chamber
being brightly illuminated the visual results definitely have the WOW
factor. The Cloud Chamber is used to clearly observe the radioactive particles."
Visit the link below to order yours now for only £369 each!
Visit web link »

07 June 2018ARCHIVED
New Promotions Available With The Launch Of Our New Catalogue!
We have some fantastic new offers to accompany the launch of our new catalogue:
FREE BISCUITS with every order - QUOTE: BISC
FREE pH CHECKER or BALANCE with orders over £250 - QUOTE: SE12 or SE13
FREE £20 Amazon Voucher with orders over £750 - QUOTE: SE20
Don't miss out on these fantastic giveaways, be sure to quote your code at checkout.
Visit web link »

25 May 2018ARCHIVED
New CLEAPSS Regulations for Gloves - We Are a Corporate Member
We have had some enquiries from customers about the new CLEAPSS regulations for gloves, detailed in their summer bulletin recently. As a corporate member of CLEAPSS, we would like to assure our customers that the gloves we supply do comply, and are labelled accordingly. We are currently in the process of updating our website with the relevant information. If you would like more information, please feel free to contact us.

15 May 2018ARCHIVED
May Star Buy - Moticam X2 WiFi Microscope Camera
This month's Star Buy has been nominated by our reps Julie and Allison.
They have chosen the Moticam X2 WiFi Microcope Camera as their top product for this month.
Find out what makes this "all in one box" product so popular with our team and our customers below.
Visit web link »
READ MORE

04 May 2018ARCHIVED
Our Brand New Catalogue is OUT NOW!
The brand new SLS Select Education catalogue is out now!
Order your copy or read it only via the link below.
We're very proud of it, and we hope you love it as much as we do. Don't forget to check out our new promotions to go along with the catalogue launch, including FREE BISCUITS with every order!
Visit web link »

10 April 2018ARCHIVED
Win Tickets To The SLS Ultimate British Garden Party!
Visit our Facebook page to be in with a chance of winning tickets to The Ultimate British Garden Party - a gala dinner with drinks and entertainment, hosted by SLS as part of the Scientific Laboratory Show & Conference 2018.
The event will take place on Tuesday 22nd May 2018 at 7pm at the De Vere Orchard Hotel at the University of Nottingham. Free overnight accommodation will be provided.
The lucky winner will win a pair of tickets to the dinner, including a three course meal, all drinks and excellent entertainment. Simply comment on the relevant post on our page to enter before 1st May 2018!
Click the link below for full terms and conditions.
READ MORE

10 April 2018ARCHIVED
April Star Buy - 3M Petrifilm Aerobic Count Plates
This month's Star Buy has been nominated by SE rep Lynn. Lynn thinks these 3M Petrifilm Aerobic Count Plates (50 plates / pk) are a great alternative to Agar Plates, and are extremely quick and easy to use.
Find out more here!
Visit web link »
READ MORE

15 March 2018ARCHIVED
March Star Buy - Lascells Ripple Tank
Our first monthly Star Buy has been suggested by SE reps Lynn and Julie. Find out what they, and their customers, love about this product here.
Visit web link »
READ MORE

13 March 2018ARCHIVED
Win a Full Body Colour MRI Scan Set During British Science Week!
To celebrate British Science Week, we're giving you the chance to win a Full Body Colour MRI Scan Set!
Simply follow us on Facebook @SLSSelectEd by 18th March to be in with a chance of winning.
Full terms and conditions on the attached PDF.
READ MORE

06 March 2018ARCHIVED
SLS Select Education Support #Techognition Week
We're proud to be supporting Preproom.org with #TECHOGNITION week, 5th - 9th March 2018.
Visit web link »
READ MORE

05 February 2018ARCHIVED
FREE balance on orders over £200!
Claim your FREE balance worth £20 on all orders over £200 by quoting SE2 when you place your order.
Visit web link »

29 January 2018ARCHIVED
10% Off Our Own Brand Chemicals!
10% off promotion only applies to our own brand chemicals – these are product codes with a ‘CHE’ prefix listed on pages 1-38 of the SLS Select Education 2017/18 catalogue.
Please quote the code SECHEM18 to benefit from the discount. For web orders please quote the code in the Message box and the discount will be applied after the order has been submitted.
Visit web link »
04 January 2018ARCHIVED
Join our Loyalty Scheme for Free Delivery
Our Select Savers loyalty scheme rewards your school’s total spend with credit for future purchases. Members are awarded a rebated credit of 2% of your accounts total spend. For example, if your school spends £10,000 with us during this academic year, the school will receive £200 to spend on goods during the next academic year.
As a Select Saver your school will also benefit from FREE DELIVERY on all orders. Find out more and register today!
Visit web link »